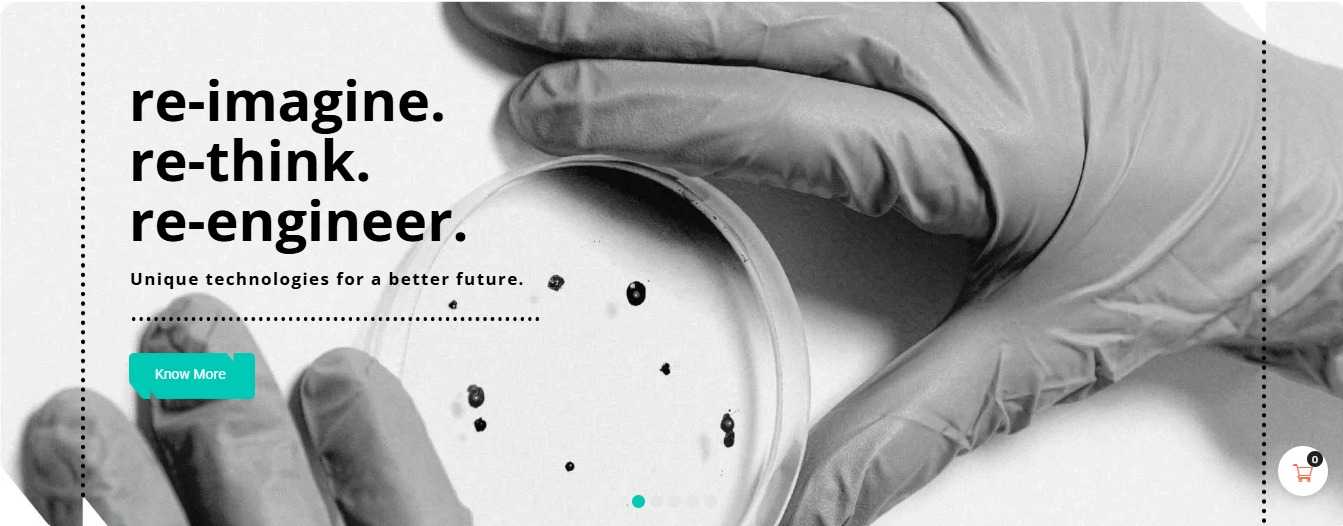
User Image
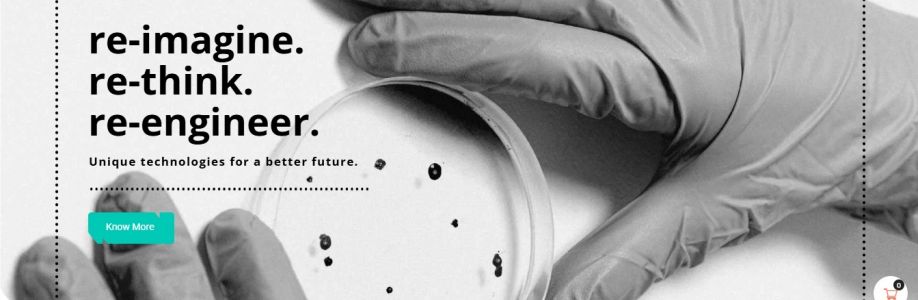
Nichem Solutions Cover Image

Nichem Solutions is an industry leader known for its innovative and eco-friendly products in areas such as plastic additives, water purification chemicals, agrochemicals, and home & personal care. Their commitment to technology-driven solutions fosters long-lasting customer relationships and sustainable practices.